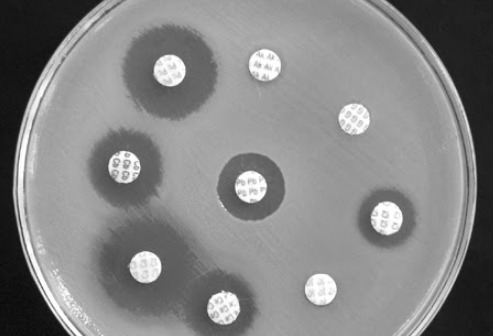

La clasificación de hemólisis se ocupa para :
¿En cuáles se dividen?(3)
Estreptococos
Alfa hemolítica (hemolisis parcial)
Beta hemolítica ( hemolisis completa)
Gamma hemolítica (NO hemólisis)

La beta hemolítica es:
La gamma hemolítica es:
Intensa en la destrucción de eritrocitos
Crece pero no destruyen eritrocitos
¿Qué clasificación utiliza el estreptococo?
Clasificación serológica (en sus proteínas o polisacáridos de la superficie)
¿Cómo puedes diferenciar si una bacteria es sensible o resistente?
Con la difusión en disco (si alrededor del disco con antibiótico no hay bacteria es por que son sensibles. Si alrededor del disco con antibiótico hay bacterias es por que son resistentes).
Los estreptococos son ______ gram______.
Si lo observamos al microscopio se ven:
cocos
positivos
Diplococos


